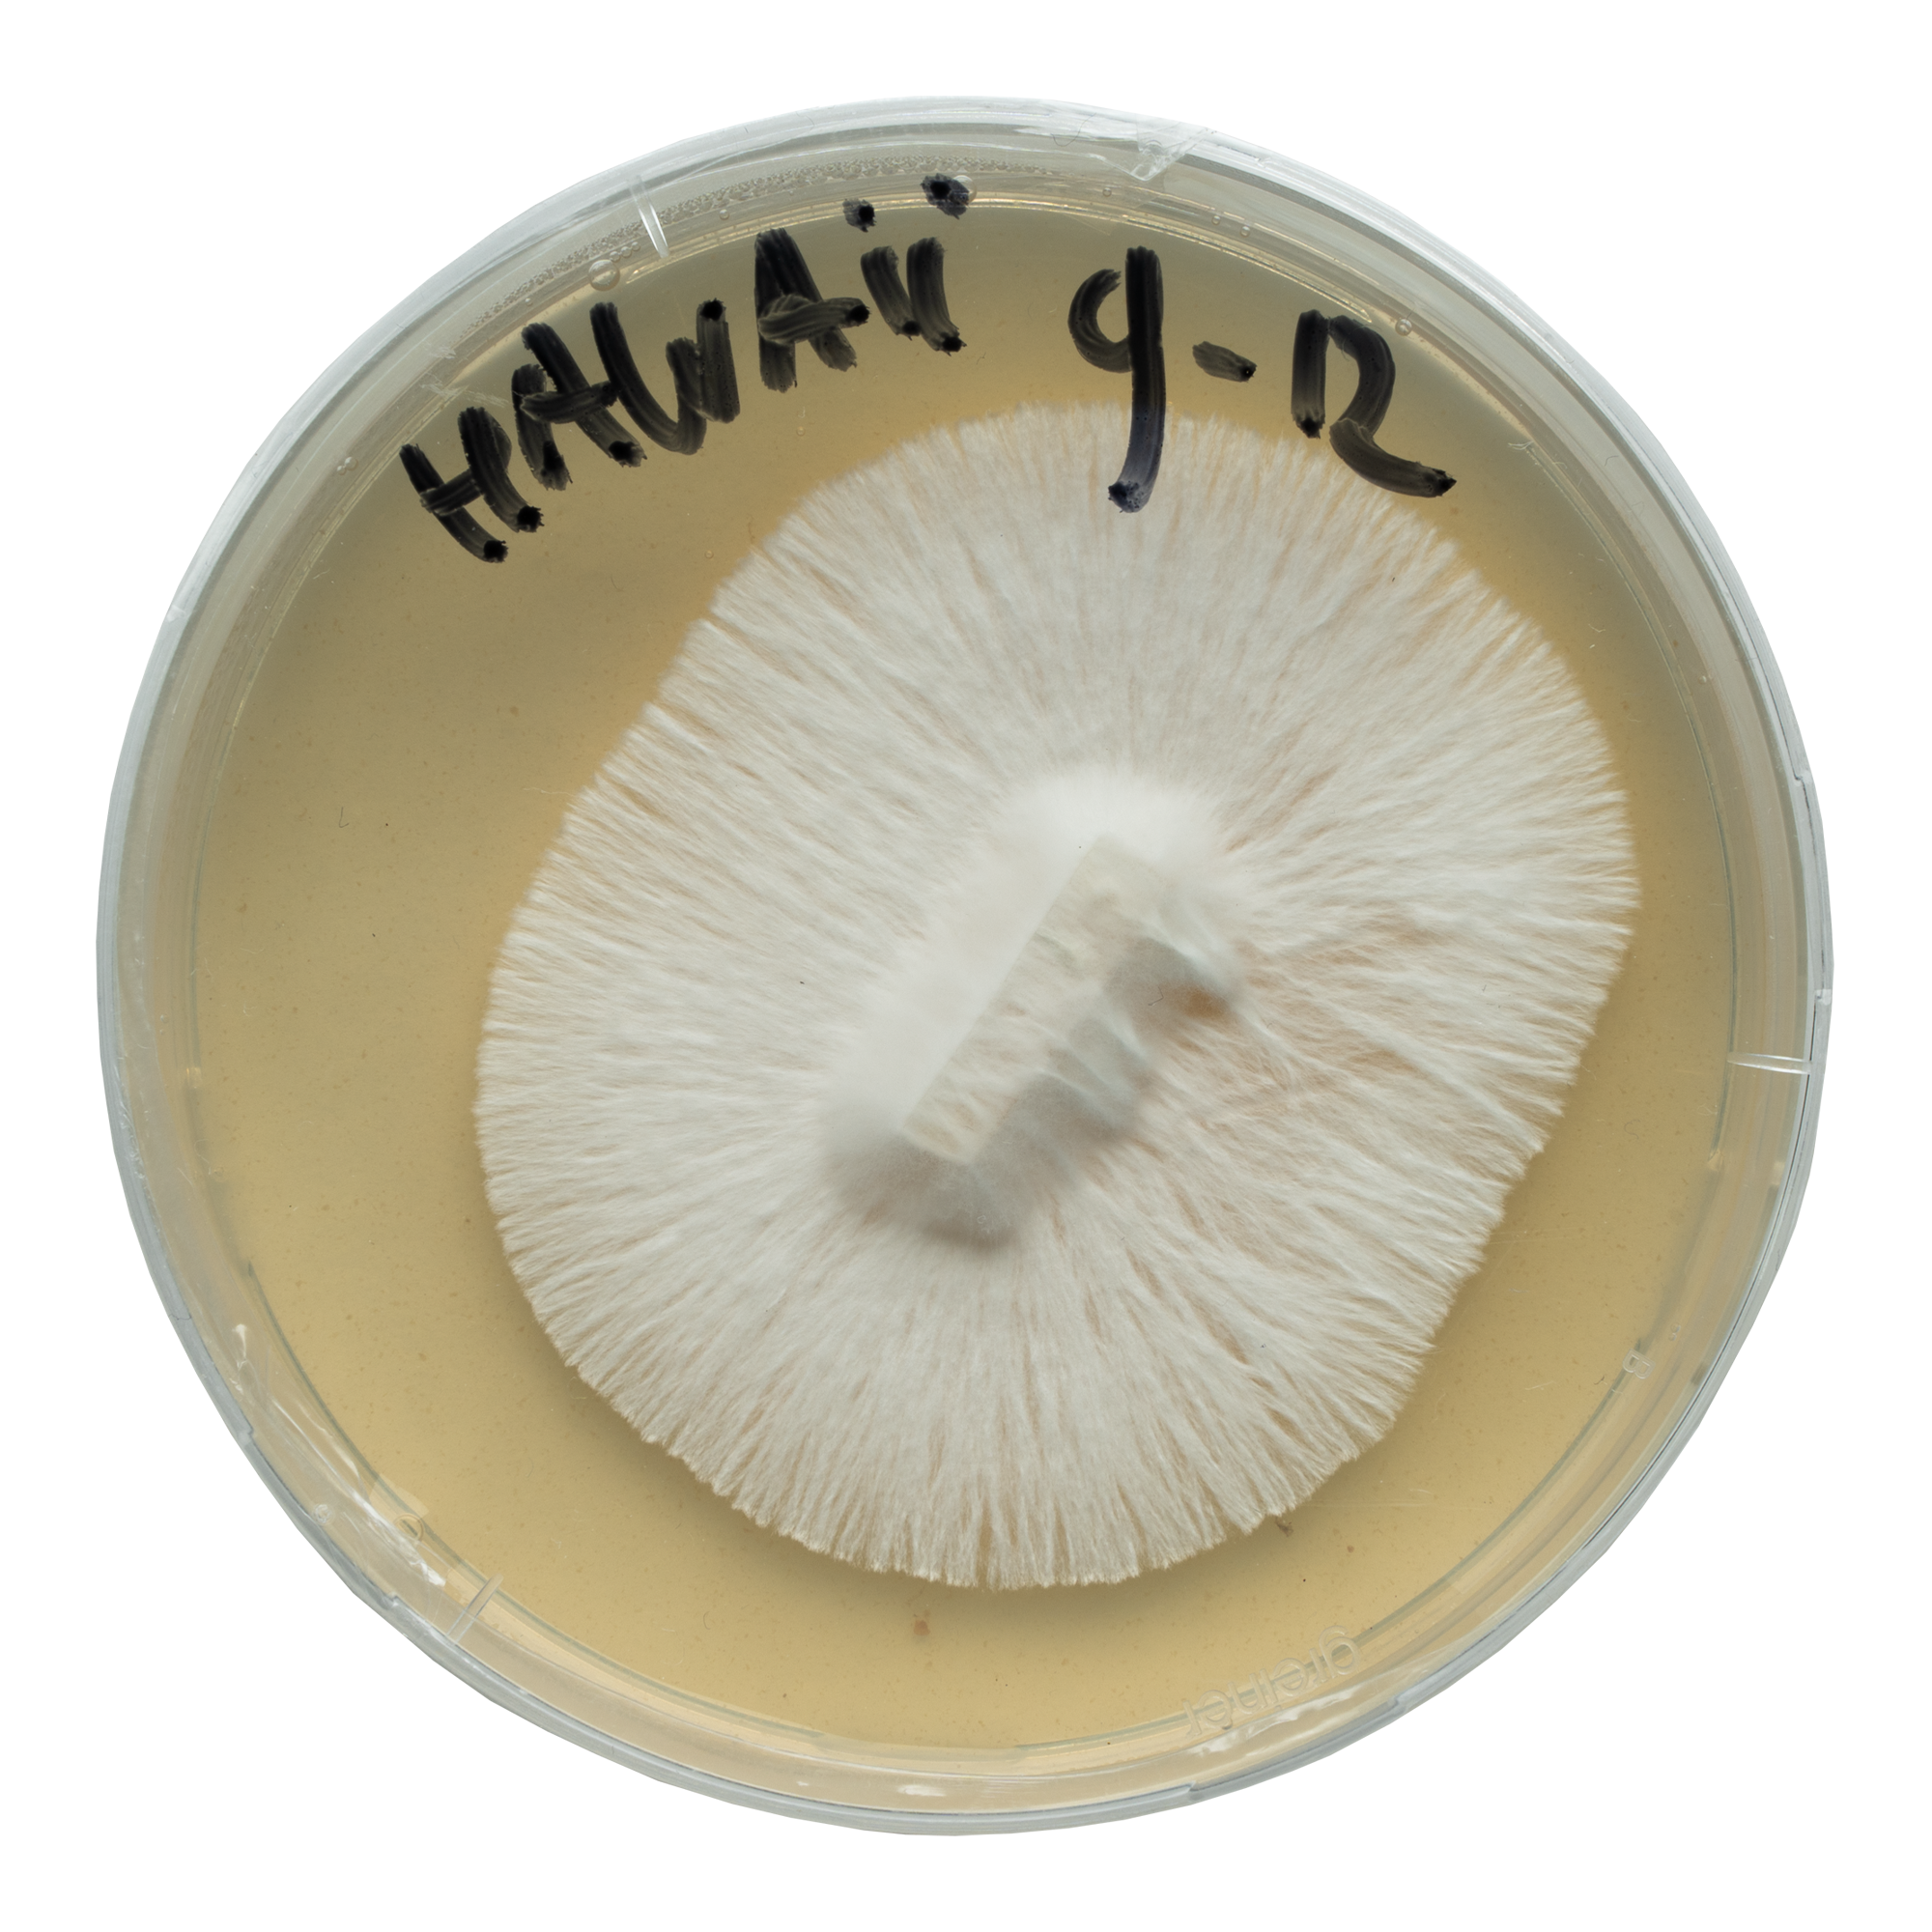

Setas mágicas Hawaiian: orígenes y genética
La cepa Psilocybe cubensis comúnmente asociada con Hawaii, a menudo llamada “PES Hawaiian”, tiene una historia intrigante. Introducida por primera vez por el distribuidor de esporas Plantasia Exotica Speciosa (P.E.S.) con sede en Honolulu, esta cepa se hizo popular por sus efectos suaves y su naturaleza indulgente.
A pesar de su nombre, Psilocybe cubensis no es nativa de Hawaii. El término “setas Hawaiian” generalmente se refiere a cultivares no oficiales, como PES Hawaiian, en lugar de variedades silvestres de las islas.
Estas setas son conocidas por su crecimiento fiable y sus efectos psicoactivos moderados. Esto las ha hecho bastante populares durante bastante tiempo, aunque sus orígenes tienen más que ver con los esfuerzos de micólogos (aficionados) que con los ecosistemas naturales de Hawaii.
Desarrollo del cultivo líquido Acid Shroomz Hawaii
Comenzamos a desarrollar nuestro cultivo líquido Hawaiian utilizando esporas Hawaiian, que germinamos en medios de nutrientes de agar. Una vez que las esporas germinaron y formaron varias colonias de micelio, seleccionamos las secciones más saludables. Estas secciones seleccionadas se añadieron a un sustrato de grano esterilizado.
Después de dos o tres semanas, el sustrato se colonizó por completo, lo que nos impulsó a estimular el micelio para producir setas. Seleccionamos un espécimen prometedor y clonamos el micelio en agar. Después de esto, sometimos el micelio a varias rondas de aislamiento, lo que resultó en un cultivo puro. Finalmente, probamos este cultivo por última vez para asegurar su alta calidad.
El cultivo Hawaii resultante coloniza los sustratos rápidamente, es resistente a la contaminación y produce setas de fuerza media. Produce setas mágicas de tamaño mediano a grande con sombreros de color caramelo y, a menudo, crece en múltiples cosechas.
Contenido del producto
Cada jeringa Hawaii contiene 20 ml de micelio vivo en una solución nutritiva cuidadosamente formulada. La jeringa es un modelo B. Braun de alta calidad para una manipulación e inoculación precisas.
Además, el embalaje del producto contiene dos toallitas con alcohol isopropílico al 70%, una aguja de jeringa estéril de 16G y un folleto de instrucciones.
Cómo usar una jeringa de cultivo líquido Hawaii
Para obtener más información, consulta nuestros artículos sobre el uso de jeringas de cultivo líquido.
Precauciones de seguridad y manipulación
Al manipular la jeringa de cultivo líquido Hawaii, es crucial seguir las precauciones de seguridad adecuadas para evitar la contaminación y asegurar un proceso de crecimiento exitoso. Aquí hay algunas pautas generales a tener en cuenta:
- Siempre manipule la jeringa en un ambiente limpio y estéril.
- Use guantes de nitrilo sin polvo y una mascarilla para evitar la contaminación.
- Asegúrese de que haya poco o ningún flujo de aire en su lugar de trabajo.
- Evite tocar la aguja o el cultivo líquido directamente para mantener la esterilidad.
- Guarde la jeringa en un refrigerador a 4-7°C para prolongar su vida útil.
Accesorios opcionales
Considere la posibilidad de utilizar una cabina de flujo laminar o una caja de aire quieto (SAB) para mayor esterilidad durante la inoculación de sustratos.
Datos generales
| Especie | Psilocybe cubensis |
| Genética | Variedad de Hawaii |
| Esporas | De púrpura a marrón |
| Aplicaciones | Microscopía, investigación y propósitos de taxonomía. |
| Nivel de habilidad | Principiante |
| Velocidad de colonización | Rápida |
| Potencia | Media |
Datos de cultivo
| Fase de desove | |
| Sustratos adecuados | Granos esterilizados como arroz integral, centeno, avena, mijo, palomitas de maíz o semillas para pájaros silvestres. |
| Tiempo de colonización | 9-14 días (tarro de litro lleno 2/3 / 27°C / agitado al 25-33% de colonización). |
| Temperatura | 25-27°C |
| Luz | Poca luz u oscuridad. |
| Fase de fructificación | |
| Sustratos adecuados | Estiércol, fibra de coco, CVG o paja (adecuadamente hidratados y tratados térmicamente). |
| Temperatura | 21-25°C |
| Humedad relativa | 80-100% |
| Intercambio de aire fresco (FAE) | Asegure un buen flujo de aire sin secar el sustrato. |
| Luz | Luz diurna indirecta o luz artificial suave (aproximadamente 6500 Kelvin). |
Notas
Este producto tiene una vida útil limitada y no es elegible para devolución. Para obtener más información, consulta nuestra página sobre el período de reflexión y las devoluciones.

Valoraciones
Aún no hay reseñas